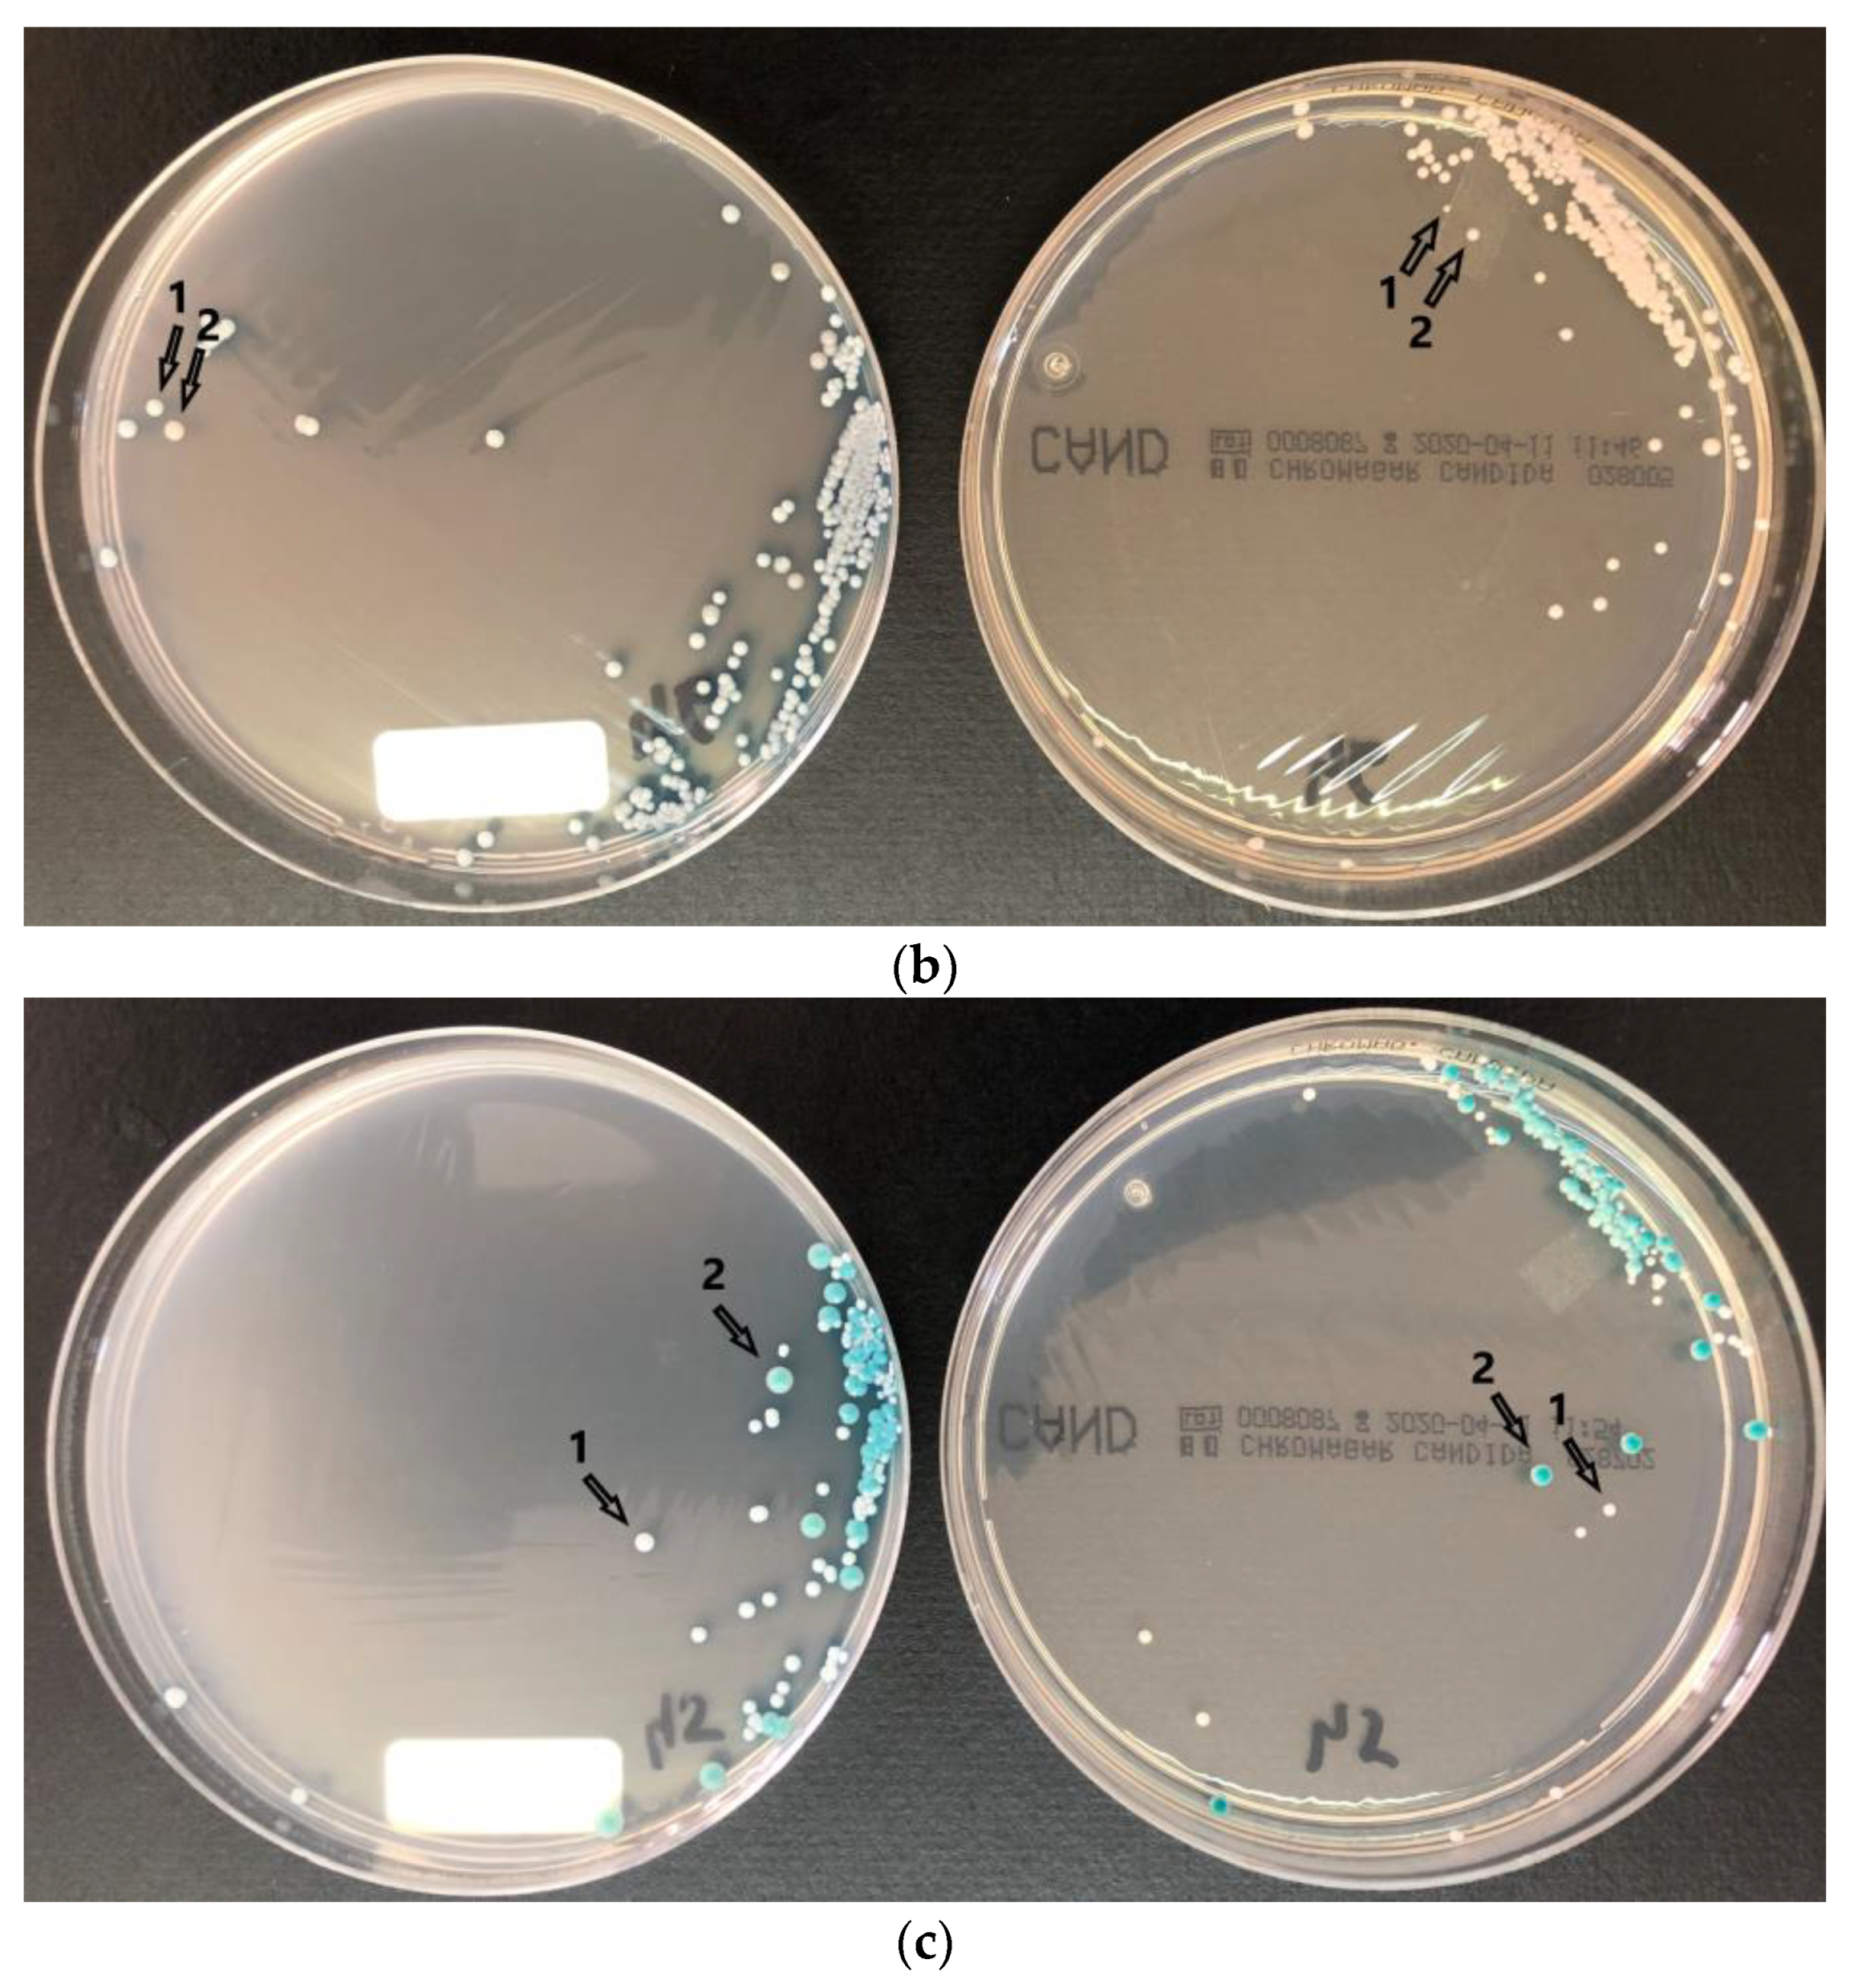

Novel Chromogenic Medium CHROMagarTM Candida Plus for Detection of Candida auris and Other Candida Species from Surveillance and Environmental Samples: A Multicenter Study
Abstract
:1. Introduction
2. Materials and Methods
3. Results
4. Discussion
5. Conclusions
Author Contributions
Funding
Institutional Review Board Statement
Informed Consent Statement
Data Availability Statement
Conflicts of Interest
References
- Yahaya, H.; Aminu, I.; Abbdullahi, S. Candida Diagnostic Platforms: Essential in Early Management of Candida Infections. Fudma J. Sci. 2021, 5, 59–71. [Google Scholar] [CrossRef]
- Fernandez, M.; Moylett, E.H.; Noyola, D.E.; Baker, C.J. Candidal Meningitis in Neonates: A 10-Year Review. Clin. Infect. Dis. 2000, 31, 458–463. [Google Scholar] [CrossRef] [PubMed]
- Pfaller, M.; Neofytos, D.; Diekema, D.; Azie, N.; Meier-Kriesche, H.-U.; Quan, S.-P.; Horn, D. Epidemiology and Outcomes of Candidemia in 3648 Patients: Data from the Prospective Antifungal Therapy (PATH Alliance®) Registry, 2004–2008. Diagn. Microbiol. Infect. Dis. 2012, 74, 323–331. [Google Scholar] [CrossRef] [PubMed]
- Ghrenassia, E.; Mokart, D.; Mayaux, J.; Demoule, A.; Rezine, I.; Kerhuel, L.; Calvet, L.; De Jong, A.; Azoulay, E.; Darmon, M. Candidemia in Critically Ill Immunocompromised Patients: Report of a Retrospective Multicenter Cohort Study. Ann. Intensive Care 2019, 9, 62. [Google Scholar] [CrossRef] [PubMed] [Green Version]
- Wisplinghoff, H.; Bischoff, T.; Tallent, S.M.; Seifert, H.; Wenzel, R.P.; Edmond, M.B. Nosocomial Bloodstream Infections in US Hospitals: Analysis of 24,179 Cases from a Prospective Nationwide Surveillance Study. Clin. Infect. Dis. 2004, 39, 309–317. [Google Scholar] [CrossRef] [PubMed] [Green Version]
- Kollef, M.; Micek, S.; Hampton, N.; Doherty, J.A.; Kumar, A. Septic Shock Attributed to Candida Infection: Importance of Empiric Therapy and Source Control. Clin. Infect. Dis. 2012, 54, 1739–1746. [Google Scholar] [CrossRef]
- Seagle, E.E.; Williams, S.L.; Chiller, T.M. Recent Trends in the Epidemiology of Fungal Infections. Infect. Dis. Clin. N. Am. 2021, 35, 237–260. [Google Scholar] [CrossRef]
- Ruiz-Gaitán, A.; Moret, A.M.; Tasias-Pitarch, M.; Aleixandre-López, A.I.; Martínez-Morel, H.; Calabuig, E.; Salavert-Lletí, M.; Ramírez, P.; López-Hontangas, J.L.; Hagen, F.; et al. An Outbreak Due to Candida auris with Prolonged Colonisation and Candidaemia in a Tertiary Care European Hospital. Mycoses 2018, 61, 498–505. [Google Scholar] [CrossRef] [Green Version]
- Schelenz, S.; Hagen, F.; Rhodes, J.L.; Abdolrasouli, A.; Chowdhary, A.; Hall, A.; Ryan, L.; Shackleton, J.; Trimlett, R.; Meis, J.F.; et al. First Hospital Outbreak of the Globally Emerging Candida auris in a European Hospital. Antimicrob. Resist. Infect. Control 2016, 5, 35. [Google Scholar] [CrossRef] [Green Version]
- Mulet Bayona, J.V.; Tormo Palop, N.; Salvador García, C.; Herrero Rodríguez, P.; Abril López de Medrano, V.; Ferrer Gómez, C.; Gimeno Cardona, C. Characteristics and Management of Candidaemia Episodes in an Established Candida auris Outbreak. Antibiotics 2020, 9, 558. [Google Scholar] [CrossRef]
- Prestel, C. Candida auris Outbreak in a COVID-19 Specialty Care Unit—Florida, July–August 2020. MMWR Morb. Mortal. Wkly. Rep. 2021, 70, 56. [Google Scholar] [CrossRef] [PubMed]
- García, C.S.; Palop, N.T.; Bayona, J.V.M.; García, M.M.; Rodríguez, D.N.; Álvarez, M.B.; del Serrano, M.R.G.; Cardona, C.G. Candida auris: Descripción de un brote. Enferm. Infecc. Microbiol. Clin. 2020, 38, 39–44. [Google Scholar] [CrossRef] [PubMed]
- Trovato, L.; Astuto, M.; Castiglione, G.; Scalia, G.; Oliveri, S. Diagnostic Surveillance by Candida albicans Germ Tube Antibody in Intensive Care Unit Patients. J. Microbiol. Immunol. Infect. 2020, 53, 778–784. [Google Scholar] [CrossRef] [PubMed]
- Morrell, M.; Fraser, V.J.; Kollef, M.H. Delaying the Empiric Treatment of Candida Bloodstream Infection until Positive Blood Culture Results Are Obtained: A Potential Risk Factor for Hospital Mortality. Antimicrob. Agents Chemother. 2005, 49, 3640–3645. [Google Scholar] [CrossRef] [PubMed] [Green Version]
- Garey, K.W.; Rege, M.; Pai, M.P.; Mingo, D.E.; Suda, K.J.; Turpin, R.S.; Bearden, D.T. Time to Initiation of Fluconazole Therapy Impacts Mortality in Patients with Candidemia: A Multi-Institutional Study. Clin. Infect. Dis. 2006, 43, 25–31. [Google Scholar] [CrossRef] [Green Version]
- Liew, Y.X.; Teo, J.; Too, I.A.-L.; Ngan, C.C.-L.; Tan, A.L.; Chlebicki, M.P.; Kwa, A.L.-H.; Lee, W. Candida Surveillance in Surgical Intensive Care Unit (SICU) in a Tertiary Institution. BMC Infect. Dis. 2015, 15, 256. [Google Scholar] [CrossRef] [Green Version]
- Piedrahita, C.T.; Cadnum, J.L.; Jencson, A.L.; Shaikh, A.A.; Ghannoum, M.A.; Donskey, C.J. Environmental Surfaces in Healthcare Facilities Are a Potential Source for Transmission of Candida auris and Other Candida Species. Infect. Control Hosp. Epidemiol. 2017, 38, 1107–1109. [Google Scholar] [CrossRef] [Green Version]
- Calvo, B.; Melo, A.S.A.; Perozo-Mena, A.; Hernandez, M.; Francisco, E.C.; Hagen, F.; Meis, J.F.; Colombo, A.L. First Report of Candida auris in America: Clinical and Microbiological Aspects of 18 Episodes of Candidemia. J. Infect. 2016, 73, 369–374. [Google Scholar] [CrossRef]
- Freydiere, A.M.; Guinet, R.; Boiron, P. Yeast Identification in the Clinical Microbiology Laboratory: Phenotypical Methods. Med. Mycol. 2001, 39, 9–33. [Google Scholar] [CrossRef]
- Perry, J.D. A Decade of Development of Chromogenic Culture Media for Clinical Microbiology in an Era of Molecular Diagnostics. Clin. Microbiol. Rev. 2017, 30, 449–479. [Google Scholar] [CrossRef] [Green Version]
- Odds, F.C.; Bernaerts, R. CHROMagar Candida, a New Differential Isolation Medium for Presumptive Identification of Clinically Important Candida Species. J. Clin. Microbiol. 1994, 32, 1923–1929. [Google Scholar] [CrossRef] [PubMed] [Green Version]
- Borman, A.M.; Fraser, M.; Johnson, E.M. CHROMagarTM Candida Plus: A Novel Chromogenic Agar That Permits the Rapid Identification of Candida auris. Med. Mycol. 2021, 59, 253–258. [Google Scholar] [CrossRef] [PubMed]
- Mulet Bayona, J.V.; Salvador García, C.; Tormo Palop, N.; Gimeno Cardona, C. Evaluation of a Novel Chromogenic Medium for Candida spp. Identification and Comparison with CHROMagarTM Candida for the Detection of Candida auris in Surveillance Samples. Diagn. Microbiol. Infect. Dis. 2020, 98, 115168. [Google Scholar] [CrossRef] [PubMed]
- Vallabhaneni, S.; Mody, R.K.; Walker, T.; Chiller, T. The Global Burden of Fungal Diseases. Infect. Dis. Clin. N. Am. 2016, 30, 1–11. [Google Scholar] [CrossRef]
- Mulet Bayona, J.V.; Tormo Palop, N.; Salvador García, C.; Fuster Escrivá, B.; Chanzá Aviñó, M.; Ortega García, P.; Gimeno Cardona, C. Impact of the SARS-CoV-2 Pandemic in Candidaemia, Invasive Aspergillosis and Antifungal Consumption in a Tertiary Hospital. J. Fungi 2021, 7, 440. [Google Scholar] [CrossRef]
- Pemán, J.; Ruiz-Gaitán, A.; García-Vidal, C.; Salavert, M.; Ramírez, P.; Puchades, F.; García-Hita, M.; Alastruey-Izquierdo, A.; Quindós, G. Fungal Co-Infection in COVID-19 Patients: Should We Be Concerned? Revista Iberoamericana De Micologia 2020, 37, 41–46. [Google Scholar] [CrossRef]
- Agrifoglio, A.; Cachafeiro, L.; Figueira, J.C.; Añón, J.M.; García de Lorenzo, A. Critically Ill Patients with COVID-19 and Candidaemia: We Must Keep This in Mind. J. Mycol. Médicale 2020, 30, 101012. [Google Scholar] [CrossRef]
- Snitkin, E.S.; Zelazny, A.M.; Thomas, P.J.; Stock, F.; NISC Comparative Sequencing Program Group; Henderson, D.K.; Palmore, T.N.; Segre, J.A. Tracking a Hospital Outbreak of Carbapenem-Resistant Klebsiella pneumoniae with Whole-Genome Sequencing. Sci. Transl. Med. 2012, 4, 148ra116. [Google Scholar] [CrossRef] [Green Version]
- Proctor, D.M.; Dangana, T.; Sexton, D.J.; Fukuda, C.; Yelin, R.D.; Stanley, M.; Bell, P.B.; Baskaran, S.; Deming, C.; Chen, Q.; et al. Integrated Genomic, Epidemiologic Investigation of Candida auris Skin Colonization in a Skilled Nursing Facility. Nat. Med. 2021, 27, 1401–1409. [Google Scholar] [CrossRef]
- Candida auris: Laboratory Investigation, Management and Infection Prevention and Control. Available online: https://www.gov.uk/government/publications/candida-auris-laboratory-investigation-management-and-infection-prevention-and-control (accessed on 31 August 2021).
- Zhu, Y.; O’Brien, B.; Leach, L.; Clarke, A.; Bates, M.; Adams, E.; Ostrowsky, B.; Quinn, M.; Dufort, E.; Southwick, K.; et al. Laboratory Analysis of an Outbreak of Candida auris in New York from 2016 to 2018: Impact and Lessons Learned. J. Clin. Microbiol. 2020, 58, e01503-19. [Google Scholar] [CrossRef] [Green Version]
- Kramer, A.; Schwebke, I.; Kampf, G. How Long Do Nosocomial Pathogens Persist on Inanimate Surfaces? A Systematic Review. BMC Infect. Dis. 2006, 6, 130. [Google Scholar] [CrossRef] [PubMed] [Green Version]
- Welsh, R.M.; Bentz, M.L.; Shams, A.; Houston, H.; Lyons, A.; Rose, L.J.; Litvintseva, A.P. Survival, Persistence, and Isolation of the Emerging Multidrug-Resistant Pathogenic Yeast Candida auris on a Plastic Health Care Surface. J. Clin. Microbiol. 2017, 55, 2996. [Google Scholar] [CrossRef] [PubMed] [Green Version]
- Clark, C.; Drummond, R.A. The Hidden Cost of Modern Medical Interventions: How Medical Advances Have Shaped the Prevalence of Human Fungal Disease. Pathogens 2019, 8, 45. [Google Scholar] [CrossRef] [PubMed] [Green Version]
- Mulet Bayona, J.V.; Salvador García, C.; Tormo Palop, N.; Gimeno Cardona, C. Validation and Implementation of a Commercial Real-Time PCR Assay for Direct Detection of Candida auris from Surveillance Samples. Mycoses 2021, 64, 612–615. [Google Scholar] [CrossRef] [PubMed]
- White, P.L.; Price, J.S.; Cordey, A.; Backx, M. Molecular Diagnosis of Yeast Infections. Curr. Fungal Infect. Rep. 2021, 15, 67–80. [Google Scholar] [CrossRef]

| Axillary–Rectal a | Axillary a | Rectal a | Pharyngeal a | Inguinal a | Nasal a | BAS | Urine | Tracheal Aspirate | |
|---|---|---|---|---|---|---|---|---|---|
| CHGUV | x | x | |||||||
| HUiP La Fe | x | x | x | x | x | x | x | x | |
| HCUV | x | x | x | x |
| Species | Color at 36–48 h, 30–37 °C, CHROMagarTM Candida Plus | Color at 48 h, 35–37 °C, CHROMagarTM Candida |
|---|---|---|
| C. albicans | Turquoise blue/green | Green |
| C. krusei | Pink to purple with white edges | Pink, fuzzy |
| C. glabrata | Pink to purple | Mauve–brown |
| C. tropicalis | Metallic blue with pink halo | Metallic blue |
| C. auris | Light blue with blue halo | White to mauve |
| C. parapsilosis complex | Light blue | White to mauve |
| C. lusitaniae | Pink to purple | White to mauve |
| Surveillance Samples (n = 364) | Environmental Samples (n = 212) | Total | ||||
|---|---|---|---|---|---|---|
| CC-Plus | CC | CC-Plus | CC | CC-Plus | CC | |
| C. albicans | 135 | 135 | 8 | 8 | 143 a | 143 a |
| C. glabrata | 76 | 77 | 7 | 6 | 83 b | 83 b |
| C. tropicalis | 19 | 19 | 0 | 0 | 19 | 19 |
| C. parapsilosis | 14 | 14 | 1 | 1 | 15 | 15 |
| C. auris | 101 | 97 | 33 | 29 | 134 | 126 |
| C. kefyr | 1 | 1 | 0 | 0 | 1 | 1 |
| C. inospicua | 2 | 2 | 0 | 0 | 2 | 2 |
| C. krusei | 8 | 8 | 0 | 0 | 8 | 8 |
| C. dubliniensis | 2 | 2 | 0 | 0 | 2 | 2 |
| Kodamaea ohmeri | 2 | 2 | 0 | 0 | 2 | 2 |
| Bacteria | 2 | 2 | 0 | 0 | 2 | 2 |
| Total number of isolates | 362 | 359 | 49 | 44 | 411 | 403 |
| Negative | 51 | 55 | 167 | 170 | 218 | 225 |
| Sensitivity (%) | Specificity (%) | PPV (%) | PNV (%) | |
|---|---|---|---|---|
| C. albicans | 99.3 | 100 | 100 | 99.8 |
| C. glabrata | 98.8 | 100 | 100 | 99.8 |
| C. tropicalis | 100 | 100 | 100 | 100 |
| C. parapsilosis | 100 | 100 | 100 | 100 |
| C. krusei | 100 | 100 | 100 | 100 |
| C. auris | 100 | 100 | 100 | 100 |
| Total | 99.5 | 100 | 100 | 99.1 |
Publisher’s Note: MDPI stays neutral with regard to jurisdictional claims in published maps and institutional affiliations. |
© 2022 by the authors. Licensee MDPI, Basel, Switzerland. This article is an open access article distributed under the terms and conditions of the Creative Commons Attribution (CC BY) license (https://creativecommons.org/licenses/by/4.0/).
Share and Cite
Mulet Bayona, J.V.; Salvador García, C.; Tormo Palop, N.; Valentín Martín, A.; González Padrón, C.; Colomina Rodríguez, J.; Pemán, J.; Gimeno Cardona, C. Novel Chromogenic Medium CHROMagarTM Candida Plus for Detection of Candida auris and Other Candida Species from Surveillance and Environmental Samples: A Multicenter Study. J. Fungi 2022, 8, 281. https://doi.org/10.3390/jof8030281
Mulet Bayona JV, Salvador García C, Tormo Palop N, Valentín Martín A, González Padrón C, Colomina Rodríguez J, Pemán J, Gimeno Cardona C. Novel Chromogenic Medium CHROMagarTM Candida Plus for Detection of Candida auris and Other Candida Species from Surveillance and Environmental Samples: A Multicenter Study. Journal of Fungi. 2022; 8(3):281. https://doi.org/10.3390/jof8030281
Chicago/Turabian StyleMulet Bayona, Juan Vicente, Carme Salvador García, Nuria Tormo Palop, Amparo Valentín Martín, Carmelo González Padrón, Javier Colomina Rodríguez, Javier Pemán, and Concepción Gimeno Cardona. 2022. "Novel Chromogenic Medium CHROMagarTM Candida Plus for Detection of Candida auris and Other Candida Species from Surveillance and Environmental Samples: A Multicenter Study" Journal of Fungi 8, no. 3: 281. https://doi.org/10.3390/jof8030281
APA StyleMulet Bayona, J. V., Salvador García, C., Tormo Palop, N., Valentín Martín, A., González Padrón, C., Colomina Rodríguez, J., Pemán, J., & Gimeno Cardona, C. (2022). Novel Chromogenic Medium CHROMagarTM Candida Plus for Detection of Candida auris and Other Candida Species from Surveillance and Environmental Samples: A Multicenter Study. Journal of Fungi, 8(3), 281. https://doi.org/10.3390/jof8030281

